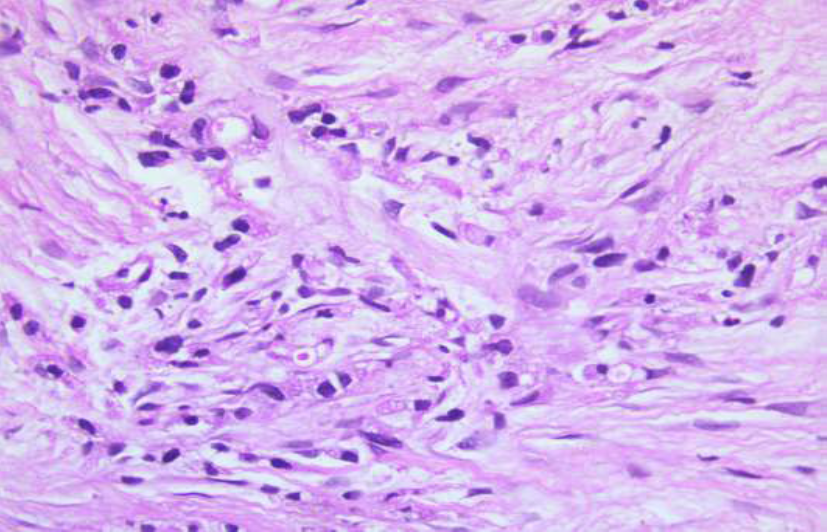

Case Report | DOI: https://doi.org/10.31579/2835-9291/021
Metastasis to Skeletal Muscle as a Primary Presentation of Gastric Adenocarcinoma
- Amit Mandal *
Department of Cardiology Christian Medical College Vellore
*Corresponding Author: Amit Mandal
Citation: Amit Mandal, (2024), Metastasis to Skeletal Muscle as a Primary Presentation of Gastric Adenocarcinoma, International Journal of Clinical Case Studies,3(3); DOI:10.31579/2835-9291/021
Copyright: © 2024, Amit Mandal. This is an open-access article distributed under the terms of the Creative Commons Attribution License, which permits unrestricted use, distribution, and reproduction in any medium, provided the original author and source are credited.
Received: 02 May 2024 | Accepted: 16 May 2024 | Published: 31 May 2024
Keywords: skeletal muscle; cancer; regional lymph nodes
Abstract
A 36-year-old gentleman presented with rapidly evolving swelling of his left thigh. MRI revealed diffusely bulky left psoas, iliacus, gluteal and left thigh muscles. His thigh muscle biopsy showed metastatic poorly differentiated mucin producing carcinoma. His supraclavicular lymph node biopsy showed features of metastatic carcinoma. An upper gastrointestinal tract endoscopy confirmed a gastric ulceration, with a biopsy positive for poorly differentiated adenocarcinoma. He did not have any GI symptoms. He was treated with palliative chemotherapy.
Skeletal muscle metastasis may be the initial presentation of gastric carcinoma and diagnosis could be challenging.
Introduction
Gastric carcinoma is one of the leading causes of cancer-related death in the world. Regional lymph nodes, liver, peritoneum, lung, and bone are the most frequent metastatic sites of gastric carcinoma. In literature, skeletal muscle metastases from gastric carcinoma have been reported rarely.[1-2] We report a case of a patient hospitalized primarily for a left thigh swelling, which was diagnosed as skeletal muscle metastases developing from gastric carcinoma.
Case Presentation
A 36-year-old gentleman was admitted due to a painful swelling of the left thigh, appearing about four months before. Biopsy done elsewhere was suggestive of chronic granulation tissue. He had been treated with multiple antibiotics and first line anti tubercular drug for 45 days elsewhere. There was no improvement in symptoms with the treatment. He was a non-smoker and his medical history was uneventful. On examination, his vital signs were stable and he did not have pallor, icterus, cyanosis, clubbing. He had 1*1 cm supraclavicular lymph node on right side. He had diffuse swelling of the left lower limb, prominent over the thigh, extending to the foot. (figure1).

Figure 1: Diffuse swelling of left thigh
There was a well-defined, 5*4 cm, freely mobile, non-tender swelling with induration of overlying skin over the right infra-clavicular area. There were no positive findings on examination of other systems.
Investigations

Myositis Profile Test Negative
He underwent a pelvic MRI that documented altered signal intensity (high signal on T2/STIR and low signal on T1) in left psoas, iliacus, obturator internus, pyriformis, gluteal and the left thigh muscles. (Figure 2).

Figure 2a: Pelvic MRI showing altered signal intensity in the left thigh muscles
He underwent FDG PET CT which showed metabolically active diffuse edema and thickening involving the left thigh muscle with soft tissue thickening and stranding in the right upper medial chest wall and a nodule in the right lower outer quadrant of breast. (Figure 2).

Figure 2b: FDG PET CT showing involvement of the left thigh muscle and a nodule in
the right lower outer quadrant of breast
Thigh muscle biopsy done elsewhere was reviewed and it showed chronic granulation tissue without any evidence of granuloma or malignant cells. Blood cultures done did not show any growth. His bone marrow biopsy was unremarkable. He underwent a left thigh muscle biopsy which showed cores of fibrocollagenous tissue with stromal infiltrates of metastatic poorly differentiated mucin producing carcinoma, on immunohistochemistry (IHC) the tumor was positive for cytokeratin 7 and negative for Cytokeratin 20, GATA3, GCDFP 15, TTF1 and CD68) raising a suspicion of a primary neoplasm of upper GI tract. (Figure 3).
Figure 3a: Photomicrographs of trucut biopsy thigh mass showing nest of tumor cells with vacuolated cytoplasm (Hematoxylin & eosin x 400)

Figure 3 b: Immunohistochemistry for cytokeratin 7 highlighting the nests of tumor cell in the biopsy of thigh mass (x90)
His supraclavicular lymph node and muscle tissue biopsy showed fibro-adipose and lymphoid tissue with occasional singly scattered large cells with eccentrically placed hyperchromatic nuclei, inconspicuous nucleoli and abundant amounts of foamy-vacuolated cytoplasm with focal PAS positive diastase resistant mucin, consistent with metastatic carcinoma. His right upper chest lesion and deep tissue biopsy showed scattered suspicious atypical cells, consistent with metastatic carcinoma. He underwent a gastroscopy to look for an underlying primary which showed an ulceration of the incisura of the stomach, (Figure 4)

Figure 4a: Gastroscopy showing an ulceration of the incisura of the stomach with irregular margins.
The histologic examination of this lesion showed poorly differentiated mucin producing adenocarcinoma of the stomach. (Figure 4)

Figure 4b: Gastric mucosal biopsy with infiltrates of tumor cells with vacuolated cytoplasm (Hematoxylin & eosin x400)

Figure 4c: Periodic acid Schiff stain of gastric mucosal biopsy showing the diastase resistant intracytoplasmic mucin. (x400)
Differential Diagnosis
36 years old gentleman presented with a symptom complex of a progressively worsening left thigh swelling extending to the left lateral abdominal wall and on examination had significant cervical lymphadenopathy with a hard swelling over the right upper chest wall.
The differentials considered were: Pyomyositis secondary to Bacterial/Tuberculosis/ atypical mycobacterial infection or Primary malignancies like soft tissue sarcoma/cutaneous lymphoma/ Metastases to muscle and infiltrative diseases like Sarcoidosis/Amyloidosis/ IgG4 disease.
Treatment
Based on these findings a diagnosis of poorly differentiated adenocarcinoma stomach with lymph node and skeletal muscle metastasis, Stage IV with negative Her2 neu on IHC was made. Medical oncology consultation was sought and was planned for palliative chemo therapy in view of the advanced stage of the disease.
Outcome And Follow-Up
Chemotherapy with CAPOX regimen was planned and he wanted to continue chemotherapy at a local centre.
Discussion
Even though skeletal muscles accounts for nearly half of human body weight and has a profound blood supply, metastasis to skeletal muscle is rare for all kinds of primary malignancies with a reported incidence of 0.03 to 0.16%.[3] Common primary malignancies that metastasize to skeletal muscle are lung cancer (25 %), gastrointestinal tumors (21 %), urological tumors (13 %), genital tumors (9.3 %), and breast cancer (8.2 %).[4] Because of their rarity , these metastases are often difficult to diagnose and are usually part of a widespread metastatic disease.
The reason for the rarity of skeletal muscle metastasis is quite inexplicit. Few proposed mechanisms are 1) accumulation of lactic acid and low pH could be an inhibitory factor for growth and proliferation of tumor cells , 2) inconstant blood flow and tissue pressure due to muscular contractions prevents attachment and settlements of tumor cells, and 3 ) lower PH values in the skeletal muscle.[5-6] Usually skeletal muscle metastasis manifests as a painful mass, but it could be an incidental finding in imaging studies in asymptomatic patients without symptoms.[3,7] In few circumstances, as in our case, it is the primary presentation of an undiagnosed malignancy, with or without any other detectable metastases.[1,2,8] In those situations when skeletal muscle metastasis is the initial presentation, the diagnosis is more challenging, as in our case. In such as situation, biopsy is considered mandatory for diagnosis. [3,9,10]
Because of the routine use of CT scan in oncologic staging most skeletal muscle metastases are detected on CT scan, however MRI is considered superior to CT scanning for detecting and characterizing muscle abnormalities. [1,9] Muscle metastatic lesions frequently reveal isointense signal to muscle, with ill-defined margins on T1-weighted MRI, and heterogeneous signal intensity with well-defined margins, in addition to peritumoral edema on T2-weighted images.[3]
Therapeutic options may include radiotherapy, chemotherapy, and surgical excision. [3,10]
Radiotherapy may effectively reduce the pain and decrease the size and surgical excision may be helpful patients with an isolated mass and in absence of other metastatic sites. [3,10] Prognosis depends on the primary tumor type, but is usually poor because of widespread metastatic disease.
In our case, the advanced pathological stage of the tumor, with sudden progression, radiotherapy or surgical excision could not be performed and he was therefore provided palliative care only.
In summary, skeletal muscle metastasis as a primary presentation of undiagnosed gastric carcinoma is a rare disease. As in our case, diagnosis may be difficult and needle biopsy is always mandatory. Any skeletal muscle mass with atypical presentation should be considered suspicious and early biopsy should be performed to avoid delay of diagnosis.
Learning Points/Take Home Messages
- Skeletal muscle metastasis as a primary presentation of undiagnosed gastric carcinoma is extremely rare
- A high index of suspicion is required for diagnosing a patient presenting with gastric carcinoma with very atypical symptoms.
- Biopsy is mandatory for diagnosis.
- Prognosis is usually poor because of widespread metastatic disease
References
- Pestalozzi BC, von Hochstetter AR. (1998). [Muscle metastasis as initial manifestation of adenocarcinoma of the stomach]. Schweiz Med Wochenschr. 128(38):1414–1417.
View at Publisher | View at Google Scholar - Rosenbaum LH, Nicholas JJ, Slasky BS, Obley DL, Ellis LD. (1984). Malignant myositis ossificans: occult gastric carcinoma presenting as an acute rheumatic disorder. Ann Rheum Dis. 43(1):95–97.
View at Publisher | View at Google Scholar - Tuoheti Y, Okada K, Osanai T, Nishida J, Ehara S, et al. (2004). Skeletal muscle metastases of carcinoma: a clinicopathological study of 12 cases. Jpn J Clin Oncol. 34(4):210–214.
View at Publisher | View at Google Scholar - Surov A, Köhler J, Wienke A, Gufler H, Bach AG, et al. (2014). Muscle metastases: comparison of features in different primary tumours. cancer imaging. 6;14(1):21.
View at Publisher | View at Google Scholar - Kamitani N, Watanabe A, Kirihataya Y, Ko S. (2018). Metachronous skeletal muscle metastasis without any other organ metastases after curative gastrectomy: a case report. Surgical Case Reports. 17;4(1):98.
View at Publisher | View at Google Scholar - Kondo S, Onodera H, Kan S, Uchida S, Toguchida J, (2002). Intramuscular metastasis from gastric cancer. Gastric Cancer. 5(2):107–111.
View at Publisher | View at Google Scholar - Imaging of the skeletal muscle metastases [Internet]. European Review. (2012).
View at Publisher | View at Google Scholar - Oba K, Ito T, Nakatani C, Okamura K, Yamaguchi H, Ajiro Y, et al. (2001). An elderly patient with gastric carcinoma developing multiple metastasis in skeletal muscle. J Nippon Med Sch. 68(3):271–274.
View at Publisher | View at Google Scholar - Tougeron D, Hamidou H, Dujardin F, Maillard C, Di Fiore F, (2009). Unusual skeletal muscle metastasis from gastric adenocarcinoma. Gastroenterol Clin Biol. 33(6–7):485–487.
View at Publisher | View at Google Scholar - Herring CL, Harrelson JM, Scully SP. (1998). Metastatic carcinoma to skeletal muscle. A report of 15 patients. Clin Orthop Relat Res. (355):272–281.
View at Publisher | View at Google Scholar
Clinic